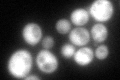
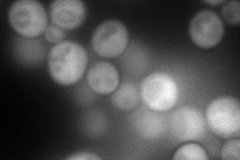
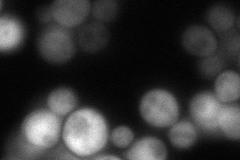
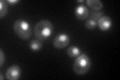

View description
Co-chaperone that binds to Hsp82p and activates its ATPase activity; similar to Hch1p; expression is regulated by stresses such as heat shock
Localization:
Intensity:
Fold change:
Significance:
-
C’ GFP library in SD
cytosol107.97 -
N' NOP1pr-GFP in SD
cytosol176.151 -
N' TEF2pr-mCherry in SD

cytosol247.859 -
N' NATIVEpr-GFP in SD
cytosol122.998 -
N' TEF2pr-VC and Cyto-VN in SD

cytosol73.3857 -
C’ GFP library in SD+DTT

cytosol168.431.55Yes -
C’ GFP library in SD+H2O2

cytosol131.241.21No -
C’ GFP library in Starvation Media
nucleusN/AN/AYes -
C’ GFP library on the background of Pup2-DaMP

cytosol -
C’ GFP library on the background of CCT mutant

cytosol139.9241.29587No
